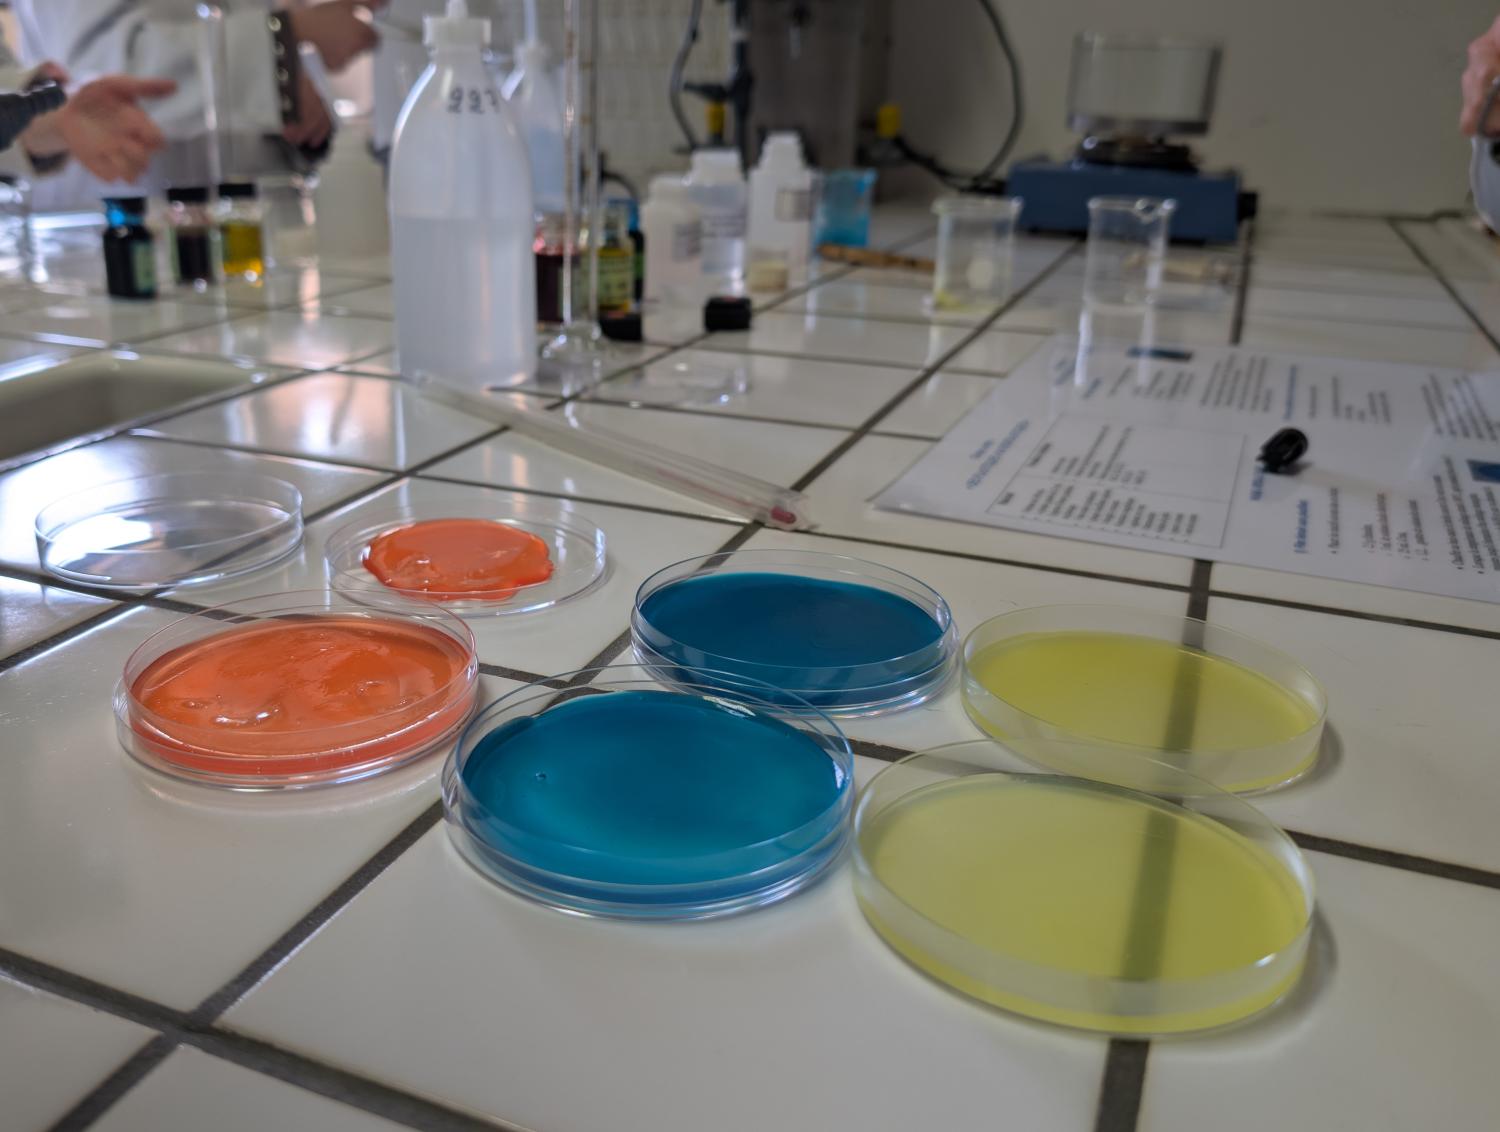

Activités
Journée Labo à l'ISI
Ce jeudi 9 avril, nos élèves de 6ème année sciences 6 se sont rendus à l'Institut Supérieur Industriel agronomique de Huy.
Une journée chargée, dynamique et hyper intéressante dans une haute école proche du Collège et offrant une diversité folle de débouchés !